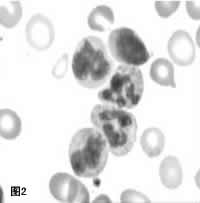
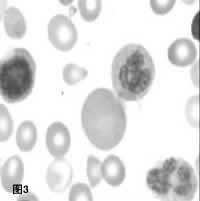

巨幼细胞性贫血
http://www.100md.com
中国医学论坛报
病例报告
患儿男,7个月,因面色苍黄、智力发育倒退1个月,发热、咳嗽3天于2002年12月入院。患儿曾在当地医治(肌注维生素B121支,2次)。营养发育史:3~4个月能抬头,现7个月不能独坐,不会爬。面部表情呆滞,对逗笑反应较前倒退。单纯母乳喂养,未添加辅食,患儿母喜素食。
入院查体 生长发育可,体重8 kg,神志清,精神反应差,表情淡漠(图1),眼神欠灵活,肢体活动少,呼吸粗重44次/分。全身皮肤蜡黄,皮肤略干燥、粗糙;面色苍黄,咽充血,无明显舌震颤;心肺查体无明显异常,腹软,肝中度肿大,脾轻度大,质软。四肢肌张力略低,肌肉略松弛,跟、膝腱反射活跃。
实验室检查 血常规:WBC 2.7~3.7×109/L,N 2%,L 94%,M 4%,RBC 1.72~1.97×1012/L,Hb 5.2~5.9g/dk,MCV 97.1~107.2 fk,PLT 85×109~101×109/L。外周血红细胞形态:红细胞大小不等,易见变形红细胞及红细胞碎片。骨髓常规分类:骨髓增生活跃,粒、红系有核细胞巨幼变,红系增生旺盛,成熟红细胞色素饱满。中性粒细胞分叶增多,可见5叶以上的中性粒细胞,有核右移、老浆幼核现象,符合巨幼细胞性贫血的骨髓改变(图2、3)。骨髓铁染色9%(正常值:>30%)。血叶酸13.5 ng/mk(3~17 ng/mk)。血VitB12 1161 pg/mk(140~960 ng/mk)。患儿母血叶酸11 ng/mk, VitB12<100 pg/mk。
, 百拇医药
讨论
刘颖中 该病例特点:(1)7个月男婴,主要表现为面色苍黄、口唇苍白1个月,伴表情呆滞,智力发育倒退。近半个月外院曾予VitB12肌注。(2)单纯母乳喂养,母亲以素食为主。(3)查体:表情呆滞,针刺反应差,贫血貌,舌面光,肝脾大,肝大为主,质软。四肢肌张力略低,肌肉略松弛,跟、膝腱反射活跃。(4)辅助检查:血常规示大细胞贫血伴白细胞、中性粒细胞、血小板减低,骨髓象符合巨幼细胞性贫血的骨髓改变,患儿血叶酸、VitB12及患儿母血叶酸水平正常,患儿母VitB12水平减低。
金玲 根据该患儿的上述临床表现和体征,以及血常规、骨髓象等考虑,虽患儿血叶酸、B12水平正常,且B12高于正常值(考虑与患儿入院前半月内曾肌注过B12有关),但患儿母亲血VitB12水平减低。故本病例诊断巨幼细胞性贫血(VitB12缺乏引起)明确。但由于该患儿血象提示三系均低,还应注意与临床表现为全血细胞减低的疾病相鉴别,如再生障碍性贫血、脾功能亢进、骨髓增生异常综合征及红白血病等。
, 百拇医药
张永红 巨幼细胞性贫血又称营养性大细胞性贫血,主要因缺乏维生素B12或叶酸引起,以成熟红细胞体积较大,中性粒细胞分叶过多和骨髓粒、红系统巨幼变为特点。在我国多见于北方农村,母乳、羊乳喂养未加辅食的婴儿。随着生活水平的提高,该病发病率明显降低。本患儿现7个月单纯母乳喂养,未添加辅食,患儿母喜素食,母体内VitB12水平明显减低,因母乳中VitB12水平与母亲血浆含量一致,若母亲缺乏VitB12则乳汁中所含浓度也低,故此成为该患儿大细胞性贫血的原因。尽管大多数巨幼贫患者为营养性的,但也可与内因子缺乏、肠道菌群过度增殖、先天性转钴蛋白Ⅱ缺乏。以及应用甲氨蝶呤等药物影响叶酸、VitB12吸收有关。本患儿外周血可见红细胞大小不等,部分红细胞染色浅淡,中心淡染区扩大,骨髓铁染色减低,考虑与患儿尚未添加辅食,并与肌注B12后红细胞增生造成相对缺铁有关。
本病治疗原则为治疗基础疾病,去除病因,并补充叶酸和VitB12。营养性巨幼细胞性贫血预后良好,但若治疗不及时VitB12缺乏合并神经系统症状者常不能完全恢复。还应注意的是因VitB12缺乏可导致神经纤维脱髓鞘改变,引起神经症状,单补叶酸会加重神经症状,因为它可使本来储量不足的VitB12更多参与叶酸的代谢而减少其在神经纤维方面作用。因此应提高警惕,早期识别本病,辨明病因,尽早给予合理治疗。
治疗经过 入院后予输压积红细胞,肌注B12 100 μg/d,口服叶酸,患儿精神反应明显好转,肢体活动增加,面部表情较前丰富,对外界反应较前明显。脾脏逐渐回缩,血网织红细胞达9.6%,Hb升至117 g/L。
刘颖中 张永红 金玲, 百拇医药
患儿男,7个月,因面色苍黄、智力发育倒退1个月,发热、咳嗽3天于2002年12月入院。患儿曾在当地医治(肌注维生素B121支,2次)。营养发育史:3~4个月能抬头,现7个月不能独坐,不会爬。面部表情呆滞,对逗笑反应较前倒退。单纯母乳喂养,未添加辅食,患儿母喜素食。
入院查体 生长发育可,体重8 kg,神志清,精神反应差,表情淡漠(图1),眼神欠灵活,肢体活动少,呼吸粗重44次/分。全身皮肤蜡黄,皮肤略干燥、粗糙;面色苍黄,咽充血,无明显舌震颤;心肺查体无明显异常,腹软,肝中度肿大,脾轻度大,质软。四肢肌张力略低,肌肉略松弛,跟、膝腱反射活跃。
实验室检查 血常规:WBC 2.7~3.7×109/L,N 2%,L 94%,M 4%,RBC 1.72~1.97×1012/L,Hb 5.2~5.9g/dk,MCV 97.1~107.2 fk,PLT 85×109~101×109/L。外周血红细胞形态:红细胞大小不等,易见变形红细胞及红细胞碎片。骨髓常规分类:骨髓增生活跃,粒、红系有核细胞巨幼变,红系增生旺盛,成熟红细胞色素饱满。中性粒细胞分叶增多,可见5叶以上的中性粒细胞,有核右移、老浆幼核现象,符合巨幼细胞性贫血的骨髓改变(图2、3)。骨髓铁染色9%(正常值:>30%)。血叶酸13.5 ng/mk(3~17 ng/mk)。血VitB12 1161 pg/mk(140~960 ng/mk)。患儿母血叶酸11 ng/mk, VitB12<100 pg/mk。
, 百拇医药
讨论
刘颖中 该病例特点:(1)7个月男婴,主要表现为面色苍黄、口唇苍白1个月,伴表情呆滞,智力发育倒退。近半个月外院曾予VitB12肌注。(2)单纯母乳喂养,母亲以素食为主。(3)查体:表情呆滞,针刺反应差,贫血貌,舌面光,肝脾大,肝大为主,质软。四肢肌张力略低,肌肉略松弛,跟、膝腱反射活跃。(4)辅助检查:血常规示大细胞贫血伴白细胞、中性粒细胞、血小板减低,骨髓象符合巨幼细胞性贫血的骨髓改变,患儿血叶酸、VitB12及患儿母血叶酸水平正常,患儿母VitB12水平减低。
金玲 根据该患儿的上述临床表现和体征,以及血常规、骨髓象等考虑,虽患儿血叶酸、B12水平正常,且B12高于正常值(考虑与患儿入院前半月内曾肌注过B12有关),但患儿母亲血VitB12水平减低。故本病例诊断巨幼细胞性贫血(VitB12缺乏引起)明确。但由于该患儿血象提示三系均低,还应注意与临床表现为全血细胞减低的疾病相鉴别,如再生障碍性贫血、脾功能亢进、骨髓增生异常综合征及红白血病等。
, 百拇医药
张永红 巨幼细胞性贫血又称营养性大细胞性贫血,主要因缺乏维生素B12或叶酸引起,以成熟红细胞体积较大,中性粒细胞分叶过多和骨髓粒、红系统巨幼变为特点。在我国多见于北方农村,母乳、羊乳喂养未加辅食的婴儿。随着生活水平的提高,该病发病率明显降低。本患儿现7个月单纯母乳喂养,未添加辅食,患儿母喜素食,母体内VitB12水平明显减低,因母乳中VitB12水平与母亲血浆含量一致,若母亲缺乏VitB12则乳汁中所含浓度也低,故此成为该患儿大细胞性贫血的原因。尽管大多数巨幼贫患者为营养性的,但也可与内因子缺乏、肠道菌群过度增殖、先天性转钴蛋白Ⅱ缺乏。以及应用甲氨蝶呤等药物影响叶酸、VitB12吸收有关。本患儿外周血可见红细胞大小不等,部分红细胞染色浅淡,中心淡染区扩大,骨髓铁染色减低,考虑与患儿尚未添加辅食,并与肌注B12后红细胞增生造成相对缺铁有关。
本病治疗原则为治疗基础疾病,去除病因,并补充叶酸和VitB12。营养性巨幼细胞性贫血预后良好,但若治疗不及时VitB12缺乏合并神经系统症状者常不能完全恢复。还应注意的是因VitB12缺乏可导致神经纤维脱髓鞘改变,引起神经症状,单补叶酸会加重神经症状,因为它可使本来储量不足的VitB12更多参与叶酸的代谢而减少其在神经纤维方面作用。因此应提高警惕,早期识别本病,辨明病因,尽早给予合理治疗。
治疗经过 入院后予输压积红细胞,肌注B12 100 μg/d,口服叶酸,患儿精神反应明显好转,肢体活动增加,面部表情较前丰富,对外界反应较前明显。脾脏逐渐回缩,血网织红细胞达9.6%,Hb升至117 g/L。
刘颖中 张永红 金玲, 百拇医药